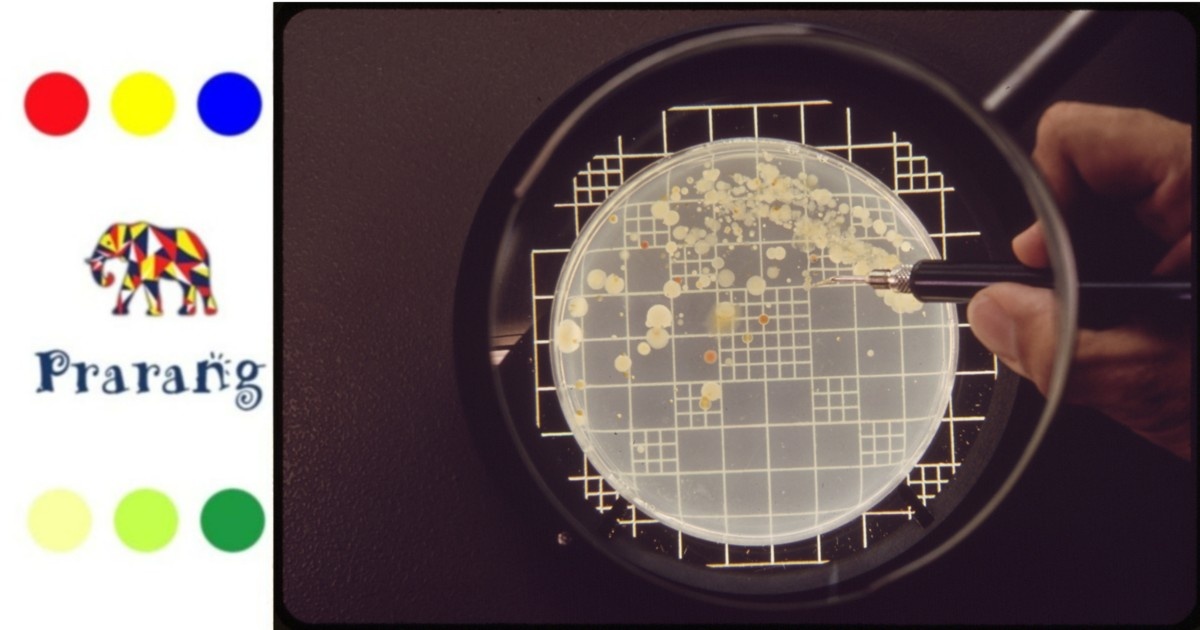
प्रदूषण नियंत्रण में बैक्टीरिया से बनी जीवित सामग्री की नई वैज्ञानिक पहल

समय - सीमा 278
मानव और उनकी इंद्रियाँ 1080
मानव और उनके आविष्कार 831
भूगोल 274
जीव-जंतु 329
समय - सीमा 278
मानव और उनकी इंद्रियाँ 1080
मानव और उनके आविष्कार 831
भूगोल 274
जीव-जंतु 329

आपने "हार्ड वर्क के बजाय स्मार्ट वर्क करों" वाली कहावत अवश्य सुनी होगी! और आज के आधुनिक तथा
तकनीक प्रधान दौर में यह कहावत, निश्चित तौर पर प्रासंगिक भी है। पुराने ज़माने में जहां किसी काम को
करने में घंटों का समय लग जाया करता था, वहीं आज वही काम मशीनों की सहायता से केवल कुछ मिनटों
में ही पूरा हो जाता है। जानवरों से जुड़े कुछ काम तो वास्तव में इतने स्मार्ट हो चुकें हैं की, इन्हे पूरा करने के
लिए आपकी उपस्थिति भी अनिवार्य नहीं है। इसका सबसे अधिक प्रासंगिक उदाहरण हमें पशु कृषि के क्षेत्र
में देखने को मिल रहा है, जहां मवेशियों से संबंधित व्यापार करने वाले आधुनिक किसान हार्ड कृषि के
बजाय स्मार्ट कृषि की ओर अग्रसर हो रहे हैं।
स्मार्ट खेती का अर्थ, कृषि में तकनीक या प्रौद्योगिकी के प्रयोग में निहित है, जिसकी शुरुआत औद्योगिक
क्रांति के बाद हो शुरू गई थी। जानकार मान रहे हैं की, आधुनिक समय में, "मोटर चालित उपकरणों को
कृत्रिम बुद्धिमत्ता (artificial intelligence (AI) से बदला जा रहा है। भारत दुनिया के सबसे बड़े दूध औरडेयरी उत्पादक देशों में से एक है। लेकिन इतने बड़े आकार के बावजूद, भारत का डेयरी उद्योग अभी भी
खंडित है। विशेषज्ञ मान रहे हैं की, डिजिटल मार्केटप्लेस (digital marketplace) किसानों को मवेशियों
की नस्लों और दूध उत्पादन को भौतिक रूप से सत्यापित करने में सक्षम बनाता है। स्टार्टअप्स (startups) के लिए, प्रौद्योगिकी कार्यान्वयन (technology implementation) एक
ऑनलाइन मार्केटप्लेस (online marketplace) के निर्माण के साथ ही समाप्त नहीं होता है। पशु कृषि
प्रौद्योगिकी के उदाहरण के तौर पर "मूफार्म ऐप (MooFarm App) और आरबीपी कार्यक्रम (RBP
Program), डेयरी किसानों को उचित पशु आहार, डेयरी फार्म प्रबंधन और डेटा रखने के लिए निर्देशित
करते है।
स्टार्टअप्स (startups) के लिए, प्रौद्योगिकी कार्यान्वयन (technology implementation) एक
ऑनलाइन मार्केटप्लेस (online marketplace) के निर्माण के साथ ही समाप्त नहीं होता है। पशु कृषि
प्रौद्योगिकी के उदाहरण के तौर पर "मूफार्म ऐप (MooFarm App) और आरबीपी कार्यक्रम (RBP
Program), डेयरी किसानों को उचित पशु आहार, डेयरी फार्म प्रबंधन और डेटा रखने के लिए निर्देशित
करते है।
मूफार्म के फाउंडर, जितेश अरोड़ा के अनुसार मूफार्म अपने मंच पर प्रत्येक मवेशी के प्रवेश की
पुष्टि करता है। मूफार्म कंपनी ने क्लासिफाइड मॉडल (classified model) के साथ शुरुआत की, जहां
किसान विज्ञापन पोस्ट कर सकते थे, और मवेशी बेच सकते थे। लेकिन आज वीडियो और इमेज-आधारित
मशीन लर्निंग (Image-Based Machine Learning (ML) मॉडल का उपयोग करके, यह पता लगाना भी
संभव है की, किस मवेशी को खरीदना है, और किसको नहीं खरीदना है।  इसके अंतर्गत एल्गोरिथम
(algorithm) एक गाय को दूसरी गाय से अलग करने के लिए स्मार्टफोन कैमरों का उपयोग कर सकती है।
इसके एल्गोरिदम किसानों को उनके स्थान और वर्ष के समय के आधार पर उनके पशुओं के लिए सर्वोत्तम
मूल्य बता सकते हैं। इस कंपनी ने पिछले दो वर्षों में 8 मिलियन से अधिक डेयरी किसानों तक पहुंचने और
850,000 मवेशियों की बिक्री में मदद करने का दावा किया है।
इसके अंतर्गत एल्गोरिथम
(algorithm) एक गाय को दूसरी गाय से अलग करने के लिए स्मार्टफोन कैमरों का उपयोग कर सकती है।
इसके एल्गोरिदम किसानों को उनके स्थान और वर्ष के समय के आधार पर उनके पशुओं के लिए सर्वोत्तम
मूल्य बता सकते हैं। इस कंपनी ने पिछले दो वर्षों में 8 मिलियन से अधिक डेयरी किसानों तक पहुंचने और
850,000 मवेशियों की बिक्री में मदद करने का दावा किया है।
कोच्चि स्थित ब्रेनवायर (brainwire) ने इसी तर्ज पर एक पशुधन स्वास्थ्य निगरानी और ट्रैकिंग प्रणाली
विकसित की है, जो इंटरनेट ऑफ थिंग्स (IoT), इयर टैग (ear tag) का उपयोग करके विटल्स और
मवेशियों के एस्ट्रस चक्र (estrous cycle) को ट्रैक कर सकती है। फिर डेटा से एमएल एल्गोरिदम (ML
Algorithm) के माध्यम से बीमारियों और गर्भावस्था के बारे में पता लगाया जाता है।
महाराष्ट्र की चितले डेयरी (Chitale Dairy) अपने कई खेतों में हजारों जानवरों की पहचान करने के लिए
रेडियो फ्रीक्वेंसी आइडेंटिफिकेशन (Radio Frequency Identification (RFID) टैग का उपयोग कर रही
है। इसने जानवरों, उनके स्वास्थ्य लाभ के साथ-साथ दूध प्रसंस्करण संयंत्रों के बारे में वास्तविक समय की
जानकारी तक पहुंच में सुधार किया है। इसी क्रम नें बेंगलुरु स्थित हाइड्रो ग्रीन एग्री सॉल्यूशंस (Hydro
Green Agri Solutions), गोदामों में तापमान और आर्द्रता के स्तर की निगरानी के लिए IoT सेंसरों को
नियोजित करती है, और किसानों के लिए उच्च गुणवत्ता वाला चारा प्रदान करने के लिए पानी और वायु
प्रवाह को नियंत्रित करती है।  हाइड्रोग्रीन्स के संस्थापक वसंत माधव कामथ के अनुसार इसके अंतर्गत
"किसानों ने हरे चारे (green fodder) का उपयोग करके, दूध की उपज में 2-3 लीटर की वृद्धि की है।"
स्मार्ट पशु कृषि में प्रौद्योगिकी का उपयोग करने का प्रमुख कारण यह है की डेयरी में गायों के लिए स्मार्ट
रोबोटिक फीडर और रोबोटिक मिल्कर्स जैसी तकनीक का उपयोग करके दुग्ध उत्पादन बिना किसी इंसानी
दखल के अधिक आसानी से स्वचालित हो सकते हैं। कंप्यूटर से जुड़े सेंसर जानवरों में संभावित स्वास्थ्य
समस्याओं को प्रकट कर सकते हैं और बीमारी के शुरुआती लक्षण खोज सकते हैं।
हाइड्रोग्रीन्स के संस्थापक वसंत माधव कामथ के अनुसार इसके अंतर्गत
"किसानों ने हरे चारे (green fodder) का उपयोग करके, दूध की उपज में 2-3 लीटर की वृद्धि की है।"
स्मार्ट पशु कृषि में प्रौद्योगिकी का उपयोग करने का प्रमुख कारण यह है की डेयरी में गायों के लिए स्मार्ट
रोबोटिक फीडर और रोबोटिक मिल्कर्स जैसी तकनीक का उपयोग करके दुग्ध उत्पादन बिना किसी इंसानी
दखल के अधिक आसानी से स्वचालित हो सकते हैं। कंप्यूटर से जुड़े सेंसर जानवरों में संभावित स्वास्थ्य
समस्याओं को प्रकट कर सकते हैं और बीमारी के शुरुआती लक्षण खोज सकते हैं। जानवरों की स्मार्ट खेती के अन्य उदाहरण के तौर पर, तुर्की के एक किसान को अपनी गायों को वीआर
हेडसेट (vr headset) पहनाया! इस उपकरण का उपयोग करने से पहले, उसे प्रतिदिन 22 लीटर दूध मिल
रहा था। फिर उनकी दो गायों ने वीआर हेडसेट का इस्तेमाल किया, जिसके बारे में उनका कहना है कि इससे
गायों का भावनात्मक बढ़ावा मिला और उनका तनाव कम हुआ, तथा उनका औसत दूध उत्पादन बढ़कर
27 लीटर हो गया।
जानवरों की स्मार्ट खेती के अन्य उदाहरण के तौर पर, तुर्की के एक किसान को अपनी गायों को वीआर
हेडसेट (vr headset) पहनाया! इस उपकरण का उपयोग करने से पहले, उसे प्रतिदिन 22 लीटर दूध मिल
रहा था। फिर उनकी दो गायों ने वीआर हेडसेट का इस्तेमाल किया, जिसके बारे में उनका कहना है कि इससे
गायों का भावनात्मक बढ़ावा मिला और उनका तनाव कम हुआ, तथा उनका औसत दूध उत्पादन बढ़कर
27 लीटर हो गया।
हालांकि सिक्के के दो पहलुओं की भांति, जानवरों की स्मार्ट खेती के फायदे और नुकसान दोनों हो सकते हैं।
कई स्मार्ट तरीके उनके लिए स्वास्थ्य संबंधी समस्याएं पैदा कर सकता है। "जानवर भी इंसानों की भांति
लंबा और सुखी जीवन जीना चाहते हैं, और भले ही हमें एहसास न हो कुछ मामलों में यह आभासी उपचार
जानवरों के लिए नैतिक बोझ साबित हो सकते है।”
संदर्भ
https://bit.ly/3F5zPRQ
https://bit.ly/3F9nKuU
https://bit.ly/3KtkJXm
चित्र संदर्भ
1 अपने मोबाइल के साथ महिला किसान को दर्शाता एक चित्रण (Flickr)
2. टैग लगी हुई गाय को दर्शाता एक चित्रण (Stockvault)
3. इयर टैग (ear tag) पहने भेड़ को दर्शाता एक चित्रण (wikimedia)
4. स्मार्ट एनिमल फार्मिंग को दर्शाता एक चित्रण (Flickr)
5. गाय के वीआर हेडसेट (vr headset) को दर्शाता एक चित्रण (youtube)

A. City Readerships (FB + App) - This is the total number of city-based unique readers who reached this specific post from the Prarang Hindi FB page and the Prarang App.
B. Website (Google + Direct) - This is the Total viewership of readers who reached this post directly through their browsers and via Google search.
C. Messaging Subscribers - This is the total viewership from City Portal subscribers who opted for hyperlocal daily messaging and received this post.
D. Total Viewership - This is the Sum of all our readers through FB+App, Website (Google+Direct), Email, WhatsApp, and Instagram who reached this Prarang post/page.
E. The Reach (Viewership) - The reach on the post is updated either on the 6th day from the day of posting or on the completion (Day 31 or 32) of one month from the day of posting.